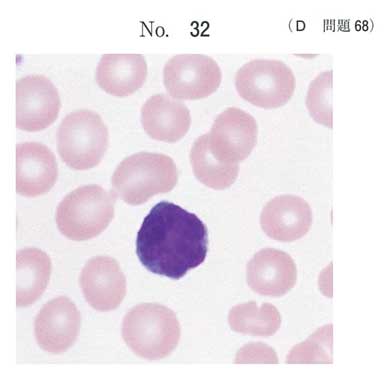

| 番号 | タイトル | コメント数 | |
|---|---|---|---|
| 1 | 113D-1 | 3 | |
| 2 | 113D-2 | 7 | |
| 3 | 113D-3 | 3 | |
| 4 | 113D-4 | 4 | |
| 5 | 113D-5 | 4 | 割問 |
| 6 | 113D-6 | 5 | |
| 7 | 113D-7 | 6 | |
| 8 | 113D-8 | 4 | |
| 9 | 113D-9 | 4 | |
| 10 | 113D-10 | 3 | |
| 11 | 113D-11 | 11 | 割問 注目 |
| 12 | 113D-12 | 3 | |
| 13 | 113D-13 | 6 | 割問 |
| 14 | 113D-14 | 1 | |
| 15 | 113D-15 | 4 | |
| 16 | 113D-16 | 5 | |
| 17 | 113D-17 | 4 | |
| 18 | 113D-18 | 6 | |
| 19 | 113D-19 | 3 | |
| 20 | 113D-20 | 2 | 割問 |
| 21 | 113D-21 | 3 | |
| 22 | 113D-22 | 5 | |
| 23 | 113D-23 | 3 | |
| 24 | 113D-24 | 5 | チョイ割 |
| 25 | 113D-25 | 2 | |
| 26 | 113D-26 | 1 | |
| 27 | 113D-27 | 2 | |
| 28 | 113D-28 | 3 | |
| 29 | 113D-29 | 3 | チョイ割 |
| 30 | 113D-30 | 3 | |
| 31 | 113D-31 | 3 | |
| 32 | 113D-32 | 5 | |
| 33 | 113D-33 | 5 | |
| 34 | 113D-34 | 3 | |
| 35 | 113D-35 | 1 | |
| 36 | 113D-36 | 3 | チョイ割 |
| 37 | 113D-37 | 2 | |
| 38 | 113D-38 | 2 | |
| 39 | 113D-39 | 3 | 割問 |
| 40 | 113D-40 | 4 | |
| 41 | 113D-41 | 3 | |
| 42 | 113D-42 | 3 | |
| 43 | 113D-43 | 2 | |
| 44 | 113D-44 | 2 | チョイ割 |
| 45 | 113D-45 | 7 | |
| 46 | 113D-46 | 1 | |
| 47 | 113D-47 | 2 | |
| 48 | 113D-48 | 1 | |
| 49 | 113D-49 | 2 | |
| 50 | 113D-50 | 1 | |
| 51 | 113D-51 | 3 | |
| 52 | 113D-52 | 3 | |
| 53 | 113D-53 | 2 | |
| 54 | 113D-54 | 2 | |
| 55 | 113D-55 | 1 | |
| 56 | 113D-56 | 1 | |
| 57 | 113D-57 | 1 | |
| 58 | 113D-58 | 1 | |
| 59 | 113D-59 | 2 | |
| 60 | 113D-60 | 3 | 割問 |
| 61 | 113D-61 | 6 | 割問 |
| 62 | 113D-62 | 2 | |
| 63 | 113D-63 | 1 | |
| 64 | 113D-64 | 5 | 割問 |
| 65 | 113D-65 | 3 | |
| 66 | 113D-66 | 2 | 割問 |
| 67 | 113D-67 | 5 | チョイ割 |
| 68 | 113D-68 | 1 | |
| 69 | 113D-69 | 5 | 割問 |
| 70 | 113D-70 | 3 | チョイ割 |
| 71 | 113D-71 | 1 | |
| 72 | 113D-72 | 2 | |
| 73 | 113D-73 | 2 | |
| 74 | 113D-74 | 3 | |
| 75 | 113D-75 | 2 |
D問題
書き込みルール »